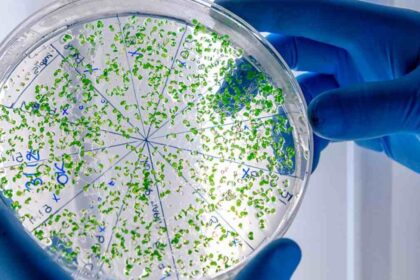

SAÚDE EM LAGARTO
Confira notícias e atualizações sobre saúde em Lagarto, incluindo informações sobre hospitais, unidades de saúde, campanhas de vacinação e ações da Secretaria Municipal.
Vacinação contra chikungunya em Lagarto começa dia 25; veja quem pode se vacinar e locais
Município é pioneiro mundial com imunizante do Instituto Butantan; doses serão destinadas ao público entre…
Caso de meningite em Sergipe acende alerta para vacinação em Lagarto
Estado confirmou a doença em paciente de 50 anos nesta quarta (11); doses contra a…

Bem-Estar em Lagarto: OX Academia: A disciplina constrói o que a motivação começa
Localizada no Largo do Cemitério, a unidade oferece ambiente moderno e equipe dedicada para acompanhar…
Vacinação contra chikungunya em Lagarto começa dia 25; veja quem pode se vacinar e locais
Município é pioneiro mundial com imunizante do Instituto Butantan; doses serão destinadas ao público entre…
Caso de meningite em Sergipe acende alerta para vacinação em Lagarto
Estado confirmou a doença em paciente de 50 anos nesta quarta (11); doses contra a…
Treine hoje para conquistar amanhã na OX Academia em Lagarto
A OX Academia oferece estrutura completa para quem busca saúde, condicionamento físico e bem-estar na…
Especialista do HUL alerta para sinais de LER/DORT em Lagarto, Sergipe
Terapeuta destaca a importância da prevenção no ambiente de trabalho e aponta desafios como subnotificação…
OX Academia dá dicas de 3 exercícios para desenvolver glúteos em Lagarto, Sergipe
Treino inclui elevação pélvica, glúteo cross e agachamento búlgaro para ganho de força e definição
Secretaria de Saúde de Lagarto promove capacitação sobre tuberculose
Treinamento reúne profissionais de Lagarto e região para fortalecer diagnóstico precoce, tratamento e controle da…
Fique conectado
Categories
Mais lidas
Patrocinado